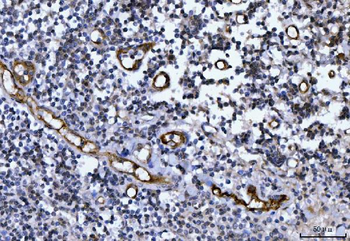
Von Willebrand Factor/VWF Antibody

You have no items in your shopping cart.
Von Willebrand Factor/VWF Antibody
Description
Images & Validation
−| Tested Applications | IF, IHC, WB |
|---|---|
| Reactivity | Mouse, Rat |
| Application Notes |
Key Properties
−| Antibody Type | Primary Antibody |
|---|---|
| Host | Rabbit |
| Clonality | Polyclonal |
| Isotype | Rabbit IgG |
| Immunogen | E.coli-derived mouse VWF recombinant protein (Position: M1304-E1452). |
| Molecular Weight | 309 kDa |
| Purification | Immunogen affinity purified. |
Storage & Handling
−| Storage | Maintain refrigerated at 2-8°C for up to 2 weeks. For long term storage store at -20°C in small aliquots to prevent freeze-thaw cycles. |
|---|---|
| Form/Appearance | Lyophilized |
| Concentration | Adding 0.2 ml of distilled water will yield a concentration of 500 μg/ml. |
| Disclaimer | For research use only |
Alternative Names
−Similar Products
−Von Willebrand Factor/VWF Antibody [orb182394]
FC, ICC, IHC, IHC-Fr, WB
Human
Rabbit
Polyclonal
Unconjugated
100 μgHuman Von Willebrand Factor (vWF) EasyStep ELISA Kit [orb2302960]
Human
15.63-1000 ng/mL
3.97 ng/mL
96 T, 48 Tvon Willebrand Factor Antibody / vWF [orb750064]
IHC-P, WB
Human
Mouse
Monoclonal
Unconjugated
20 μg, 100 μg

Quality Guarantee
Explore bioreagents carefree to elevate your research. All our products are rigorously tested for performance. If a product does not perform as described on its datasheet, our scientific support team will provide expert troubleshooting, a prompt replacement, or a refund. For full details, please see our Terms & Conditions and Buying Guide. Contact us at [email protected].

Anti-VWF Picoband antibody, IHC(P): Mouse Liver Tissue.

Anti-VWF Picoband antibody, Western blotting. All lanes: Anti VWF at 0.5 ug/ml. WB: Mouse Lung Tissue Lysate at 50 ug. Predicted bind size: 309 KD. Observed bind size: 309 KD.

Anti-VWF Picoband antibody, Western blotting. All lanes: Anti VWF at 0.5 ug/ml. WB: Recombinant Mouse VWF Protein 0.5 ng. Predicted bind size: 37 KD. Observed bind size: 37 KD.

IF analysis of VWF and alpha-Smooth Muscle Actin using anti-VWF antibody and anti-alpha-Smooth Muscle Actin antibody. VWF and alpha-Smooth Muscle Actin a paraffin-embedded section of rat lung tissue. Heat mediated antigen retrieval was performed in EDTA buffer (pH8.0, epitope retrieval solution). The tissue section was blocked with 10% goat serum. The tissue section was then incubated with 2 µg/mL rabbit anti-VWF antibody and mouse anti-alpha-Smooth Muscle Actin Antibody overnight at 4°C. DyLight®488 Conjugated Goat Anti-Rabbit IgG and Cy3 Conjugated Goat Anti-Mouse IgG were used as secondary antibody at 1:100 dilution and incubated for 30 minutes at 37°C. The section was counterstained with DAPI. Visualize using a fluorescence microscope and filter sets appropriate for the label used.

IF analysis of VWF using anti-VWF antibody. VWF was detected in paraffin-embedded section of rat liver tissue. Heat mediated antigen retrieval was performed in EDTA buffer (pH8.0, epitope retrieval solution). The tissue section was blocked with 10% goat serum. The tissue section was then incubated with 2 µg/mL rabbit anti-VWF Antibody overnight at 4°C. DyLight®488 Conjugated Goat Anti-Rabbit IgG was used as secondary antibody at 1:100 dilution and incubated for 30 minutes at 37°C. The section was counterstained with DAPI. Visualize using a fluorescence microscope and filter sets appropriate for the label used.

IHC analysis of VWF using anti-VWF antibody. VWF was detected in paraffin-embedded section of rat lung tissues. Heat mediated antigen retrieval was performed in citrate buffer (pH6, epitope retrieval solution) for 20 mins. The tissue section was blocked with 10% goat serum. The tissue section was then incubated with 1 µg/ml rabbit anti-VWF Antibody overnight at 4°C. Biotinylated goat anti-rabbit IgG was used as secondary antibody and incubated for 30 minutes at 37°C. The tissue section was developed using Strepavidin-Biotin-Complex (SABC) with DAB as the chromogen.
Quick Database Links
UniProt Details
−Documents Download
Request a Document
Protocol Information
Von Willebrand Factor/VWF Antibody (orb234319)
Participating in our Biorbyt product reviews program enables you to support fellow scientists by sharing your firsthand experience with our products.
Login to Submit a Review